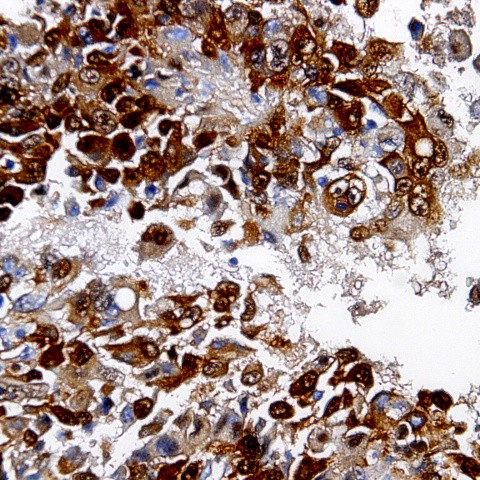
Desmin Antibody in Immunohistochemistry (Paraffin) (IHC (P))

Search
AbboMax
Desmin Polyclonal Antibody
{{$productOrderCtrl.translations['antibody.pdp.commerceCard.promotion.promotions']}}
{{$productOrderCtrl.translations['antibody.pdp.commerceCard.promotion.viewpromo']}}
{{$productOrderCtrl.translations['antibody.pdp.commerceCard.promotion.promocode']}}: {{promo.promoCode}} {{promo.promoTitle}} {{promo.promoDescription}}. {{$productOrderCtrl.translations['antibody.pdp.commerceCard.promotion.learnmore']}}
图: 1 / 2
Desmin Antibody (602-300) in IHC (P)


产品信息
602-300
种属反应
宿主/亚型
分类
类型
抗原
偶联物
形式
浓度
规格
纯化类型
保存液
内含物
保存条件
运输条件
产品详细信息
Positive control: Cardiac Myocyte
Cellular location: Cytoplasmic and membrane.
靶标信息
Desmin (approximately 53 kDa) exhibits a high degree of tissue specificity, its expression being predominantly confined to all types of muscle cells (cardiac, skeletal and smooth muscle). Regulation of desmin expression is stage and tissue-specific, since it is induced during terminal development of, for example, skeletal muscle cell differentiation. In skeletal en cardiac muscle cells desmin is localized in the Z-disk region and at the intercalated disk. The expression pattern of desmin in smooth muscle is much more heterogenous. Coexpression of vimentin and desmin has been observed in tumors derived from muscle tissue, i.e. rhabdomyosarcomas and leiomyosarcomas. Furthermore, during myocard dysfunction dramatic changes in the distribution of desmin have been observed.
仅用于科研。不用于诊断过程。未经明确授权不得转售。
篇参考文献 (0)
生物信息学
蛋白别名: cardiomyocyte intermediate filament protein; cardiomyopathy, dilated 1F (autosomal dominant); cardiomyopathy, dilated 1I; CMD1I; Desmin; epididymis secretory sperm binding protein; FLJ12025; FLJ39719; FLJ41013; FLJ41793; intermediate filament; intermediate filament protein; MFM1; muscle specific intermediate filament; SCPNK; unnamed protein product
基因别名: CDCD3; CSM1; CSM2; DES; LGMD1D; LGMD1E; LGMD2R
UniProt ID: (Human) P17661, (Rat) P48675, (Mouse) P31001
Entrez Gene ID: (Human) 1674, (Rat) 64362, (Mouse) 13346